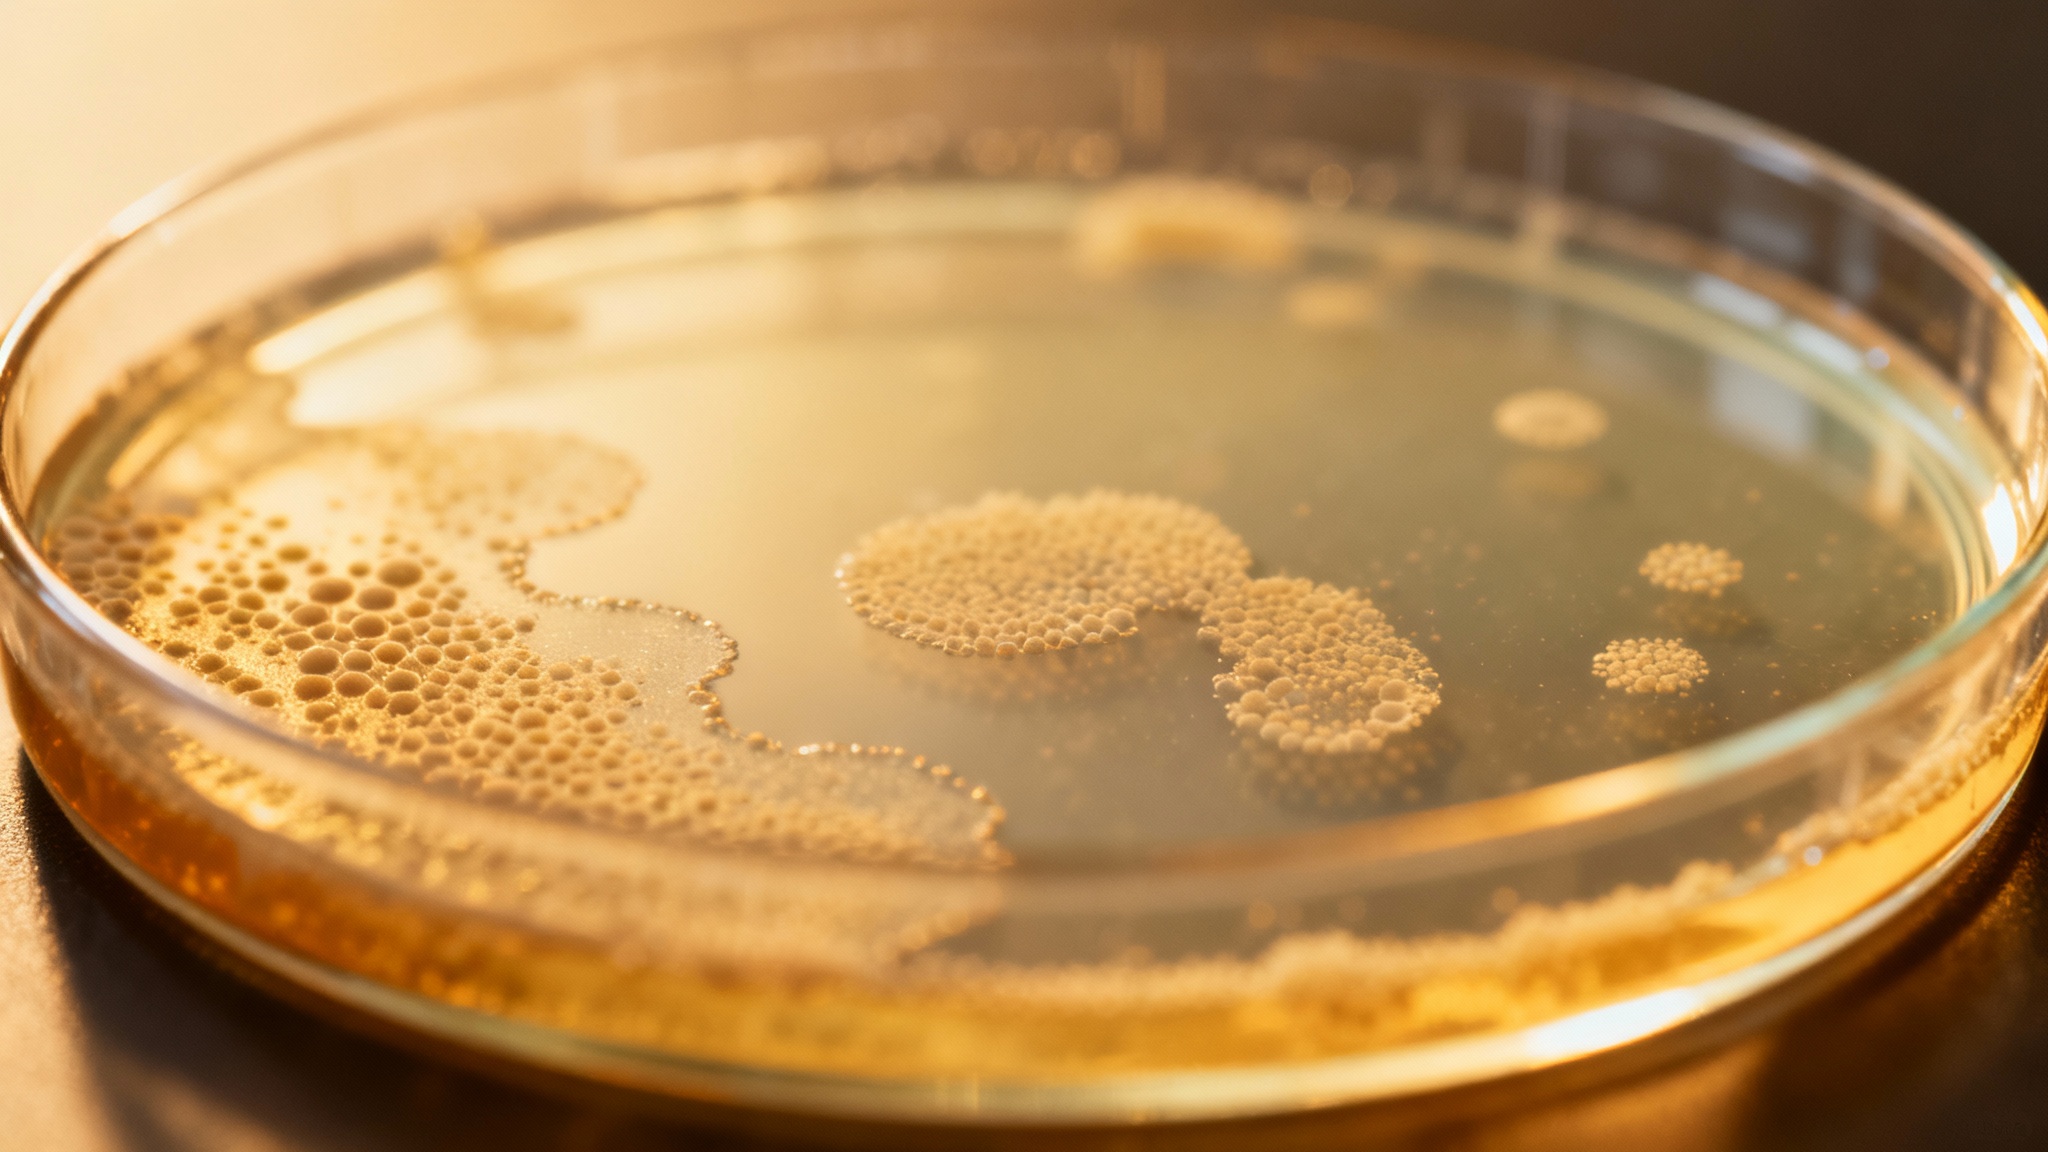

Des scientifiques ont peut-être trouvé le moyen d’éradiquer la maladie infectieuse la plus mortelle au monde
Auteur: Mathieu Gagnon
Un vieil ennemi qui refait surface
Avant même de parler du COVID-19, il y avait la tuberculose. Une maladie respiratoire qui nous accompagne depuis au moins 9 000 ans. Elle a fait des ravages en Europe aux 18e et 19e siècles, emportant des milliers de vies chaque année. On la croyait sur le déclin, presque une histoire ancienne, mais détrompez-vous. Le CDC la considère toujours comme la maladie infectieuse la plus meurtrière au monde.
Et le pire, c’est qu’elle revient en force, même là où on ne l’attendait plus. Des cas réapparaissent aux États-Unis, en Californie, au Kansas… un peu partout. Pendant la pandémie de COVID, la situation n’a fait qu’empirer, car les gens hésitaient à se rendre dans les centres de soins. Ce qu’on ignorait jusqu’à présent, c’est que cette bactérie, Mycobacterium tuberculosis, a une faiblesse, un talon d’Achille génétique. Et les scientifiques, croyez-moi, sont bien décidés à en profiter.
Le cœur et les poumons de la bactérie
Une équipe de recherche menée par Shelley Haydel, une microbiologiste de l’Université d’État de l’Arizona, a mis le doigt sur quelque chose de crucial. La bactérie responsable de la tuberculose possède un système moléculaire dont elle ne peut absolument pas se passer pour survivre. Ce système s’appelle PrrAB. Pour faire simple, c’est un peu comme le cœur et les poumons du microbe. Si on l’arrête, tout s’arrête.
Ce PrrAB, c’est lui qui régule les gènes essentiels à la respiration de la bactérie. C’est grâce à lui qu’elle produit son énergie, l’ATP, en utilisant de l’oxygène. Sans cette énergie, la bactérie est tout simplement… morte. C’était la cible parfaite, celle qu’on cherche depuis si longtemps.
CRISPR : l’interrupteur qui éteint la maladie

Alors, comment ont-ils fait pour l’éteindre ? L’équipe a utilisé une technologie de pointe appelée CRISPRi (pour interférence CRISPR). C’est un outil génétique incroyable qui permet de « réprimer » certains gènes, en gros de les mettre en sourdine. En ciblant le système PrrAB avec CRISPRi, ils ont réussi à l’éteindre complètement. Et le résultat a été radical.
Une fois le PrrAB désactivé, la bactérie n’a pas survécu. C’est aussi simple que ça. Dans les cultures en laboratoire, cette méthode a réduit la quantité de bactéries de près de cent fois. C’est un peu ironique, n’est-ce pas ? Pour tuer une bactérie qui s’attaque à nos poumons, il faut s’attaquer à son propre système respiratoire. C’est ce qu’on appelle un juste retour des choses.
Une arme supplémentaire : le médicament DAT-48

Mais ce n’est pas tout. Il existe une autre piste contre la tuberculose. Un composé expérimental, le Diarylthiazole-48 (ou DAT-48 pour les intimes), était déjà connu pour tuer la bactérie. On sait maintenant pourquoi : il agit en inhibant, lui aussi, le fameux système PrrAB.
Les chercheurs ont eu l’idée de combiner les deux approches. Et là, surprise : en utilisant le DAT-48 en même temps que la répression par CRISPRi, ils ont tué encore plus de bactéries. En fait, en désactivant le PrrAB, la bactérie devient beaucoup plus sensible au médicament. C’est une synergie parfaite. Même sans l’intervention génétique, le DAT-48 s’est révélé plus puissant lorsqu’il était associé à d’autres médicaments antituberculeux existants.
Un espoir immense, mais la route est encore longue
« Ces résultats mettent en évidence le PrrAB comme un centre de régulation essentiel et valident le DAT-48 comme un candidat prometteur pour une thérapie ciblée », a déclaré Shelley Haydel dans l’étude publiée. C’est une avancée majeure, vraiment. On a enfin compris où frapper.
Il faut toutefois rester prudent. Pour l’instant, toutes ces expériences ont été menées en laboratoire, in vitro comme on dit. Elles n’ont pas encore été testées sur des êtres humains. Il faudra encore du temps pour voir si ces traitements sont efficaces et sûrs chez les patients. Mais l’espoir est bien là, et il est immense.
Vers la fin de la tuberculose ?

Alors, est-ce la fin de la tuberculose ? On a le droit de rêver. Cette découverte place le système PrrAB au cœur d’une nouvelle stratégie de lutte contre la maladie. On a non seulement identifié une vulnérabilité critique, mais on dispose aussi d’un composé, le DAT-48, qui semble taillé sur mesure pour l’exploiter.
Si ces traitements s’avèrent efficaces chez l’homme, on pourrait assister à un tournant historique. Peut-être qu’un jour, la tuberculose rejoindra la variole dans les livres d’histoire, comme une de ces maladies terribles que l’humanité a réussi à vaincre. Le chemin est encore long, mais pour la première fois depuis bien longtemps, il semble enfin bien tracé.
Ce contenu a été créé avec l’aide de l’IA.